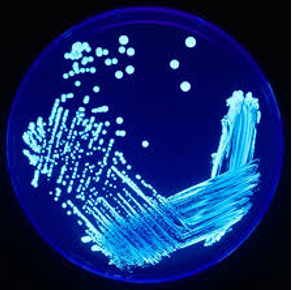

Magyar nyelven a Legionella-szabvány
2020. április 1-jén megjelent magyar nyelven az MSZ EN ISO 11731 Vízminőség. Legionella megszámlálása (ISO 11731:2017) nemzeti szabvány. Az MSZT 2017-ben angol nyelven vezette be e szabványt, mely az MSZ EN ISO 11731-2:2008 helyébe lépett.
2020. április 1-jén megjelent magyar nyelven az MSZ EN ISO 11731 Vízminőség. Legionella megszámlálása (ISO 11731:2017) nemzeti szabvány. Az MSZT 2017-ben angol nyelven vezette be e szabványt, mely az MSZ EN ISO 11731-2:2008 helyébe lépett.
A dokumentum a vízmintákban előforduló Legionella izolálására és megszámlálására szolgáló tenyésztéses módszereket írja le.
A legionellák nyomon követése közegészségügyi szempontból fontos, hogy azonosíthatók legyenek azok a környezeti források, amelyek a legionellózis szempontjából kockázatot jelenthetnek, mint például az evaporatív hűtőtornyok, az épületek melegvíz- és hidegvíz-rendszerei és a kapcsolódó berendezések, pl. levegőztetett medencék, fogászati kezelőegységek, klímaberendezések stb. A korábbiakkal ellentétben az új szabvány minden típusú víz esetén alkalmazható, beleértve a hálózati vizeket, az ipari vizeket, a szennyvizeket és a természetes vizeket.
E kiadás újdonsága továbbá, hogy a leírt módszerek alkalmazhatók a vízhez kapcsolódó mátrixokhoz is (pl. biofilmekhez, üledékekhez stb.).
A szabvány elsősorban a közvetlen szélesztéses és a membránszűréses módszerekre fókuszál, az ún. lemosásos módszert kevésbé tárgyalja, de arra is kínál megoldást.
A szabvány négyféle mintafeldolgozást sorol fel:
- közvetlen szélesztés (10 000 TKE/l várható csíraszám felett);
- membránszűrés (tenyésztés a filteren);
- membránszűrés (ún. lemosásos módszer);
- hígítás (erősen szennyezett minták esetében).
A szabvány kitér arra is, hogy a mintavételt az ISO 19458 szerint kell elvégezni, és figyelmeztet arra, hogy a szélsőséges hőmérsékleteket (fagyás vagy túlmelegedés) a mintavételtől a minta feldolgozásáig kerüljük el. Fontos újítás a szabványban, hogy konkrét javaslatot tesz a különböző típusú minták feldolgozási lehetőségeire.
Zajdon Anna
2020. április